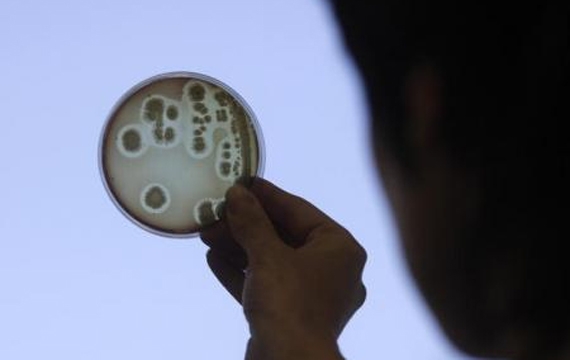

البكتيريا المعوية "إي كولاي" تغزو الولايات المتحدة
امتد تفشي البكتريا المعوية (إي كولاي) المرتبط بمطاعم شركة (تشيبوتلي مكسيكان جريل) إلى 3 ولايات أمريكية أخرى ليرتفع عدد الولايات المتضررة إلى تسع ولايات حيث قال 47 شخصا من بين 52 أصيبوا بالنزلة المعوية أنهم أكلوا في سلسلة المطاعم الشعبية قبل ان يصابوا بالمرض. وعدلت المراكز الأمريكية لمكافحة الأمراض والوقاية منها بياناتها وأضافت أربع حالات جديدة مرتبطة بسلسلة مطاعم تشيبتولي التي تتخذ اجراءات مشددة لضمان سلامة مأكولاتها.
وأدى التلوث إلى تراجع أسعار أسهم الشركة 5% ثم قللت الخسائر إلى 3% لتصل إلى 548.13 دولار للسهم في مطلع الاسبوع. وأضافت السلطات الأمريكية ولايات ايلينوي وماريلاند وبنسيلفانيا إلى قائمة الولايات التي سجلت المرض. وكانت القائمة تضم 6 ولايات متضررة هي كاليفورنيا ومينيسوتا ونيويورك واوهايو واوريجون وواشنطن. ولا يزال المحققون الذين يبحثون عن مصدر التلوث يواجهون "تحديات كبيرة" في التوصل إلى أسباب العدوى. وهم يشتبهون في منتج من الأطعمة الطازجة شحن من موقع ما الى عدة مطاعم.
وقالت المراكز الأمريكية إن ما يقدر بنحو 48 مليون أمريكي يمرضون كل عام بسبب العدوى التي تنتقل عن طريق الغذاء ومنهم 128 ألفا ينقلون للمستشفيات ويتوفى منهم ثلاثة آلاف كل عام. وذكر مركز العلم في خدمة المصلحة العامة وهو جهاز رقابي انه لم يتم التوصل إلى مصدر العدوى إلا في نحو 40% فقط من تفشي الأمراض التي تنتقل عن طريق الغذاء في الفترة من عام 2002 الى عام 2011. وثمة توجه متزايد بين المطاعم ومنها (تشيبوتلي) لاستخدام الأغذية الطازجة غير المصنعة وهو أمر سليم من ناحية التغذية لكن الخبراء يقولون إنه ينطوي على مخاوف لان عمليات الطهي تقتل الميكروبات التي تنقل الأمراض.